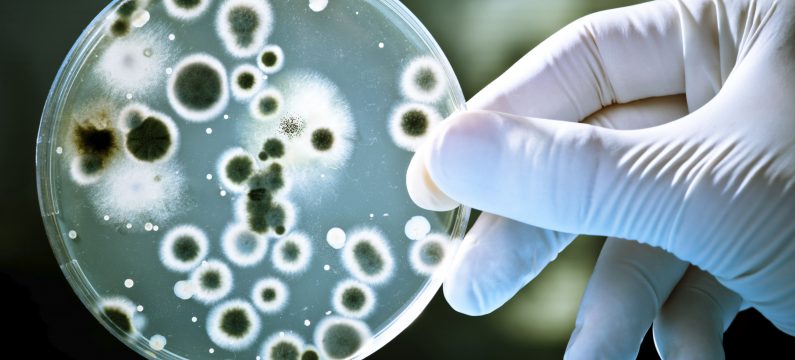

Vlada Unsko-sanskog kantona izdvojila je u prošloj godini blizu 290 hiljada KM za zdravstvenu zaštitu životinja i u svrhu naknade štete za ubijene životinje. Pozitivna vijest je da je broj zaraženih životinja drastično smanjen.
Prema riječima ministra privrede i šumarstva USK Sulejmana Kulenovića, ostalo je namjenskih sredstava od prošle godine i ona će biti prebačena za 2020. godinu.
“Bilo je dosta manje zaraznih bolesti u 2019. godini u odnosu na 2018. godinu pa samim tim je bilo i manje eutanazija. Posebno je bilo manje slučajeva bruceloze koja je prethodnih godina bila ogroman problem. Tako je došlo do smanjenja utroška sredstava”, rekao je Kulenović.
Ostalo je oko 61 hiljada KM i ta sredstva će biti utrošena u prevenciju i eventualno za eutanaziju oboljelih životinja. Ministar Kulenović rekao je kako je do smanjenja oboljelih životinja došlo zbog kontinuiranog rada veterinara na terenu, ali i da su vremenske prilike išle u korist.
Ovo ministarstvo bi na nekoj od narednih sjednica trebalo predstaviti i svoj izvještaj i analizu za prošlu godinu u kojoj se, između ostalog, navodi kako se stanje u sektoru stočarstva i proizvodnje mlijeka pogoršava. više od 1.000 malih proizvođača je ugasilo svoju proizvodnju u Cazinu koji važi za najvećeg prozivođača, ali je značajan i broj onih koji su ugasili proizvodnju mlijeka u Bužimu.
Prema riječima ministra Kulenovića, u 2019. godini proizvedeno je manje milion i po litara mlijeka u odnosu na 2018. godinu, a broj grla je smanjen za oko 200.
Predstavnici udruženja poljoprivrednika iz Krajine iz godine u godinu upozoravaju kako je sve manje malih poljoprivrednih proizvođača koji se bave ratarstvom, proizvodnjom jagodičastog voća itd.